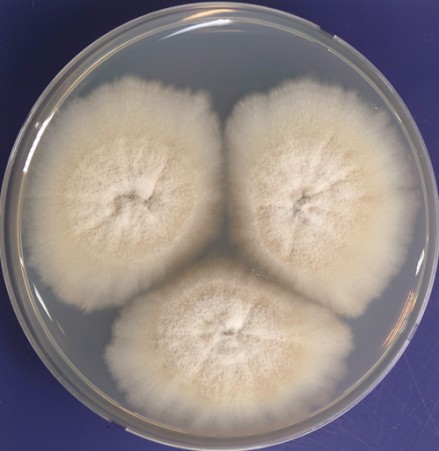
▲주름 개선 다당류를 생산하는 해양곰팡이 지벨루롭시스 세라이 배양 사진. (사진제공=국립해양생물자원관)

▲주름 개선 다당류를 생산하는 해양곰팡이 지벨루롭시스 세라이 배양 사진. (사진제공=국립해양생물자원관)
자원관은 해양바이오뱅크에 등록된 곰팡이 ‘지벨루롭시스 세라이(Gibellulopsis serrae)’에서 다당류를 추출해 주름 개선 효과를 확인했다. 이 곰팡이를 다양한 영양분을 이용해 배양한 결과, 포도당을 사용할 때 높은 다당류 생산량을 보였다. 이는 다당류 산업화의 걸림돌인 낮은 생산량 문제를 개선할 수 있는 최적 영양 조건을 찾아낸 성과다.
다당류는 여러 개의 당이 사슬처럼 연결된 물질로, 동ㆍ식물 뿐만 아니라 세균·곰팡이 같은 미생물에서도 만들어진다. 현재 해조류나 세균에서 얻은 다당류가 식품, 의약, 화장품 등의 산업에 폭넓게 활용되고 있으나 해양곰팡이 유래 다당류 연구 사례는 적어 새로운 산업 소재로의 활용 가능성이 큰 분야로 평가된다.
김현태 관장은 “앞으로도 해양곰팡이가 가진 가능성을 탐구해 다양한 바이오 소재 개발로 이어질 수 있도록 노력하겠다”고 말했다.



